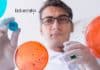
TMC-Centre For Cancer Epidemiology JRF & SRF Recruitment TMC Jobs

CSIR-IMTECH Parkinson’s Disease Project Recruitment, Apply Online
CSIR IMTECH Project Vacancy, Online Application Process
CSIR IMTECH Project Vacancy, Online Application Process. Project Associate Recruitment. MSc Biological, Life & Natural Sciences Job. Interested...
CSIR-NEERI Project Associate Jobs For Biotech, Life Sciences & Microbiology
CSIR-NEERI Project Associate Jobs For Biotech, Life Sciences & Microbiology
CSIR-NEERI Project Associate Jobs For Biotech, Life Sciences & Microbiology. PhD Microbiology/Biotechnology/ Life Sciences applicants...
NIPER Life Sciences Job With Rs. 50,000 pm Pay, Applications Invited
NIPER BioNEST Life Sciences Technical Manager Job, Applications Invited
NIPER BioNEST Life Sciences Technical Manager Job, Applications Invited. MSc/ BTech Life Sciences Technical Manager job...
CSIR-NCL MSc & BTech Project Biotech, Life Sciences Recruitment, Apply Online
NCL Biotech/Life Sciences Project Associate Job, Apply Online
NCL Biotech/Life Sciences Project Associate Job, Apply Online. NCL Pune is hiring B.Tech./M.Sc Degree in Biochemistry/ Biotechnology/...
NII Cancer Research Program Recruitment For MSc & MTech Life Sciences
NII Cancer Research Program Job For MSc & MTech Life Sciences
NII Cancer Research Program Job For MSc & MTech Life Sciences. Recruitment of Life...
Govt ILS Life Sciences Quality Control Consultant With Rs. 60,000 pm Pay
Life Sciences QC Job With Rs. 60,000 pm at ILS
Life Sciences QC Job With Rs. 60,000 pm at ILS. PhD Life Sciences Jobs. Institute...
Jamia Hamdard University Admissions Open: MSc in Medical Virology & MSc Biomedical Sciences
PG Medical Virology Course at Jamia Hamdard University
The Jamia Hamdard University, New Delhi has launched a new two years postgraduate (PG) course, M.Sc. (Masters...
Junior Research Fellow Position Under DBT Funded Ramalingaswami Re-entry Fellowship Project at BITS Pilani,...
Ramalingaswami Re-entry Fellowship Project JRF Post at BITS Pilani, Goa
Ramalingaswami Re-entry Fellowship Project JRF Post at BITS Pilani, Goa. Interested and eligible applicants can...
FSSAI Recruitment 2021: 50+ Food Safety Officer, Analyst Vacancies
FSSAI Recruitment 2021: 50+ Food Safety Officer, Analyst Vacancies
FSSAI Recruitment 2021: 50+ Food Safety Officer, Analyst Vacancies. FSSAI Direct Recruitment 2021. Food analyst exam....
Biotecnika Times Newsletter 04.01.2021 – Summer Research Fellowship Program 2022, Govt HP
Biotecnika Times - Summer Research Fellowship Program 2022, Govt HP
Summer Research Fellowship Program for Students and Teachers 2022 - Download Biotecnika to Apply
SRFP 2022...
TIFR GS2022 Exam Alert For MSc / Int.PhD / PhD Admissions
TIFR GS2022 Exam Alert For MSc / Int.PhD / PhD Admissions
TIFR GS2022 Exam Alert For MSc / Int.PhD / PhD Admissions. The application link...
The Shekhar Suman Show – India’s 1st Bioscience Talk Show
The Shekhar Suman Show - India's 1st Bioscience Talk Show
Dear Biotecnikans
As promised we have for you dear subscribers The Shekhar Suman Show. This is...
Science Academies Summer Research Fellowship Program for Students and Teachers 2022
SRFP 2022 - Summer Research Fellowship Program 2022
SRFP 2022 - Summer Research Fellowship Program 2022. Science Academies Summer Research Fellowship Program for Students and...
NIBMG Genomics and Drug Discovery Project Recruitment, Apply Online
NIBMG Bioinformatics/ Biophysics Jobs - Online Application Process
NIBMG Bioinformatics/ Biophysics Jobs - Online Application Process. NIBMG - National Institute of Biomedical Genomics is hiring...
ICAR-IARI Research Fellow Recruitment, Attend Walk-In-Interview
ICAR-IARI Research Fellow Recruitment, Attend Walk-In-Interview
ICAR-IARI Research Fellow Recruitment, Attend Walk-In-Interview. MSc Biotechnology/ Molecular Biology/ Biochemistry/ Plant Science/ Life Sciences can apply for research...